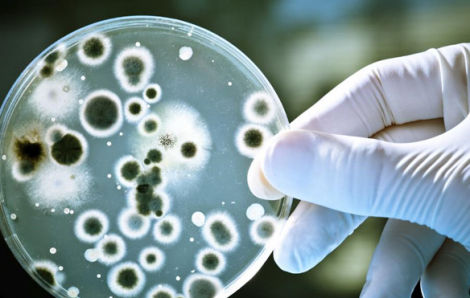
3,5 triệu người có thể tử vong vì nhiễm khuẩn bệnh viện mỗi năm

Kết quả tìm kiếm cho "sinh vien tu vong"
Kết quả 1 - 12 trong khoảng 96

Cách nhập viện 1 ngày, em D. bị sốt, nhức đầu nên uống thuốc hạ sốt và đi học, sau đó choáng váng, khó thở, rơi vào nguy kịch.

Ngày 17/10, Bệnh viện Đa khoa Bà Rịa thông tin vụ một nam sinh gặp tai nạn giao thông được đưa đến bệnh viện và đã tử vong.

2 bé sinh đôi 19 tháng ở Hà Nội rơi xuống ao, dù được đưa đi cấp cứu, song 2 bé không qua khỏi.

Trẻ sơ sinh nhập viện khi được 2 ngày tuổi, sau khi mổ lấy thai ở tuần 37 theo yêu cầu của gia đình để “chọn ngày, giờ đẹp”.

Viện trưởng Viện KSND Tối cao đã ban hành quyết định hủy 2 quyết định của tỉnh Vĩnh Long bác khiếu nại của gia đình nữ sinh bị tai nạn tử vong…
Dự báo đến năm 2050, gần 3,5 triệu người trên thế giới có thể tử vong do nhiễm khuẩn bệnh viện mỗi năm.

Tổ chức y tế Thế giới (WHO) cảnh báo việc cắt giảm viện trợ khiến các dịch vụ thiết yếu cho sức khỏe bà mẹ, trẻ sơ sinh trở nên khan hiếm.

Liên quan đến vụ nữ tài xế lái Mercedes tông hàng loạt xe máy ở TP Thủ Đức, 1 nạn nhân nữ đã tử vong sau khi được điều trị tại BV.

Bệnh viện Phụ sản Trung ương cho biết đang rà soát, xem xét lại thái độ nhân viên y tế và xử lý nghiêm nếu vi phạm.

Một thầy giáo đã bị tạm dừng giảng dạy để báo cáo giải trình liên quan đến sự việc nam sinh viên trường cao đẳng bị điện giật tử vong.

Trong lúc đang học thực hành, nam sinh Trường cao đẳng Đắk Lắk được đưa đến bệnh viện cấp cứu vì bị điện giật nhưng đã tử vong.

Ngành chức năng tỉnh Vĩnh Long đang điều tra, làm rõ vụ nam sinh tử vong tại sân Trường Đại học Xây dựng miền Tây.